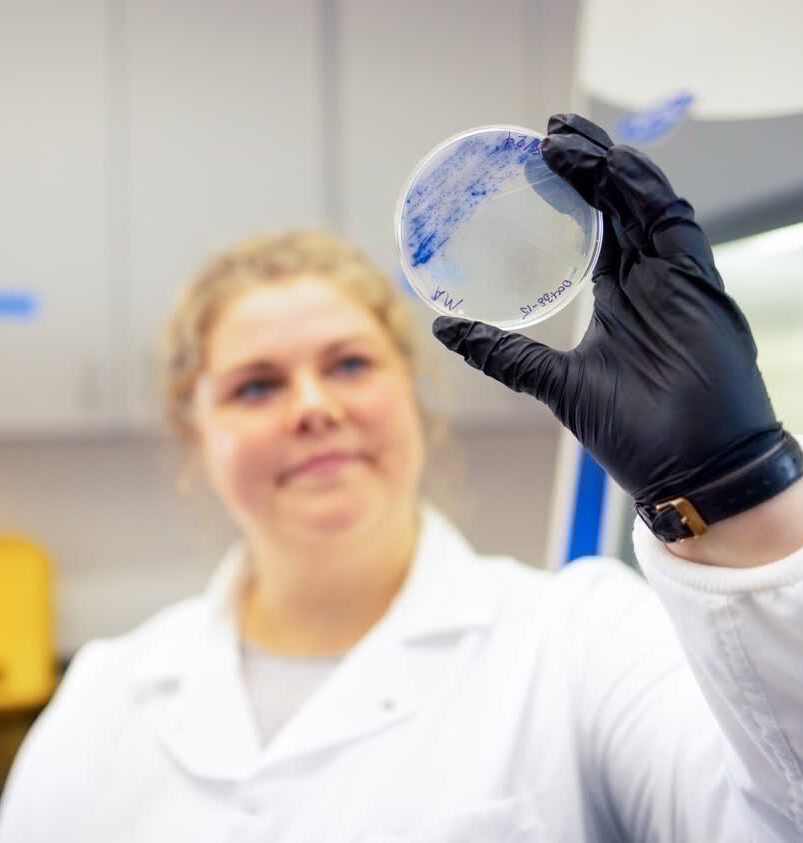
Dr. Kirstie Francis holds up a petri dish with blue microbial cultures growing on it.

At Mote Marine Laboratory, our biomedical and technology development research is dedicated to unlocking the oceans’ most powerful secrets.
Our innovators investigate new marine sources of medicine, novel methods to reduce the impacts of red tide and other harmful algae, and smart strategies and tools to take the pulse of our oceans. To achieve our goals, Mote recruits and nurtures the best and brightest scientists in our field—often by leading state- or national-level, multi-partner initiatives to tackle complex challenges head on.
We translate and transfer our innovations to grow the ocean economy and drive the development of a Silicon Valley of marine science and technology.